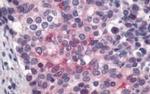
LPAR4 Antibody in Immunohistochemistry (Paraffin) (IHC (P))

Search
Invitrogen
LPAR4 Polyclonal Antibody
{{$productOrderCtrl.translations['antibody.pdp.commerceCard.promotion.promotions']}}
{{$productOrderCtrl.translations['antibody.pdp.commerceCard.promotion.viewpromo']}}
{{$productOrderCtrl.translations['antibody.pdp.commerceCard.promotion.promocode']}}: {{promo.promoCode}} {{promo.promoTitle}} {{promo.promoDescription}}. {{$productOrderCtrl.translations['antibody.pdp.commerceCard.promotion.learnmore']}}
产品信息
PA1-32651
宿主/亚型
分类
类型
抗原
偶联物
形式
浓度
规格
保存条件
运输条件
RRID
产品详细信息
PA1-32651 detects GPR23 from human samples.
靶标信息
EDG4 belongs to a family of G-protein coupled receptors whose ligands are lysophospholipids. There are eight known members of the EDG receptor family and they are implicated in mediating growth-related effects such as induction of cellular proliferation, alterations in differentiation and survival, and suppression of apoptosis. They also evoke cellular effector functions that are dependent on cytoskeletal responses such as contraction, secretion, adhesion and chemotaxis. EDG receptors are developmentally regulated and differ in tissue distribution. They couple to multiple types of G proteins to signal through ras and MAP kinase, rho, phospholipase C, and several protein tyrosine kinases. EDG4 is expressed in testes, ovarian tumor, and leukocyte containing tissues.
仅用于科研。不用于诊断过程。未经明确授权不得转售。